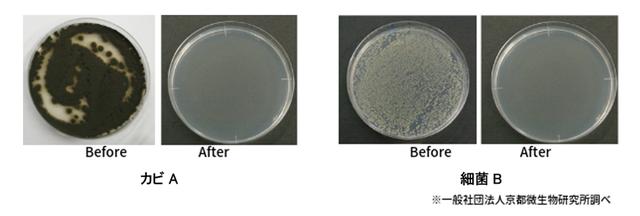

プロジェクト実行者
ストーリー
- 悪臭とバイキンのパラダイス(楽園)と化した みんなの靴を根こそぎ除菌。
- 画期的なアミノ酸除菌という手法で靴の中のバイキンと悪臭を元から分解する。
- 毎日の使用で蓄積した汗と角質がこびりついた 「お前のその靴本当に大丈夫なのか??」


う、うぐっ・・・

く、くさいぃぃぃぃ・・・・
お前はこんな経験をしたことはないだろうか?
靴を脱いだ瞬間、何とも言えない生あたたかい発酵臭に襲われ周りの大切な方にこんな表情をされたことはないだろうか?
そんなお前に、最新ケミカル素材から生まれたアミノ酸除菌スプレー『お前のその靴、大丈夫か!?』をぜひとも知ってもらいたい。

” お前のその靴、大丈夫か!? ”
居酒屋で座敷に上がる時・・・
一日履いたそのムレムレの靴から悪臭が出てないか?

そのままにしておくと・・・カビなどの温床に・・・・
そして・・・気になる彼女に悪影響が・・・・
” 奥さんのその靴、大丈夫か!? ”
男女関わらず、靴は悪臭の原因だ!毎朝こっそり自分と奥さんの靴をこいつで守れ!!臭いの根源を断ち切るのだ!

” 子どものその靴、大丈夫か!? ”
一番最悪なのは子ども達の靴だ!!雨の日、砂場、部活動で汗まみれ・・・・
あああああ~~~~絶対臭い!!

そんな足の臭さで悩んでいる野郎どもよ!!
俺が開発した最新ケミカル素材から生まれた〝 アミノ酸除菌スプレー『お前のその靴、大丈夫か!?』 ”を試してみないか!!
※パッケージは現在開発段階!

テストや安全試験をしっかりとクリアした、最新の除菌剤!! 普段は病院の手術室や医療器具の除菌に使われている。一般の世界ではほとんど知られていないのだ!!
しかし!! この除菌剤には一つの欠点が!!
それは即効性に乏しいこと!!
毎朝毎朝、会社や学校に出かける前や、帰った後にシュッシュと習慣的に靴に吹きかけなければならない!!
はっきり言って面倒くさい!!
しかし!! そこをクリアすれば、君の靴に寄生しているあんにゃろう達を確実に追い詰めることができる!! 君たちには輝かしい良臭(りょうしゅう)の未来が待っているのだ!
俺も出張で商品探索をしていると1日20㌔近く歩くんだ!! 雪駄じゃなくて革靴の時はもう最悪!! 靴の中はむれっむれ!! 靴を脱ぐと・・・
ああああ・・・想像したくない!!

そんな状況でもこいつがあれば心配ない!!


「なぜ、おまえの靴が臭くなるのかを知っているか???」
我々の身体には常に菌が寄生している!!
その菌のことを通称「常在菌」という。 常に存在している菌で「常在菌」。
その菌が、汗や古くなった角質を分解する際にあの嫌な臭いが発生する。
最初は足だけだから洗えば済むが、そのうち、その菌は「靴の常在菌」と化すのである!!
そう!!” お前の”足 ”から” お前の靴 ”へ繁殖するのだ!! 靴に乗り移った常在菌は脅威である!!
お前のその靴・・・大丈夫か!?足の臭いの2大原因物質の正体とは??
皆は足の臭いの原因物質を知っているか?
靴の中から納豆の臭いを感じたことはあるか?
その臭いの成分は、「イソ吉草酸 」(いそきっそうさん)!!
まさに納豆菌が発生させる納豆臭である!!

俺はあの匂いが大嫌いである!!
でも、息子は毎日俺の横で夕飯に美味しそうに納豆を食べている!! 健康にいいから何も言えない… 食わず嫌いの俺がただわるいだけである・・・
納豆好きのみなさま、申し訳ございません。
話は脱線したが・・・
もう一つのツ~~~~ンとくる、きつい臭い・・・
それは、お酢と同じ「酢酸」である。
常在菌は、お前たちの汗と角質などを栄養にして、この厄介な” 納豆臭 ” & ” 酸っぱい酢酸臭 ”を放っているのだ!
その靴に乗り移った常在菌をしっかり撃退できるのがこいつ!


お前たちは ” アミノ酸除菌 ” という言葉を聞いたことがあるだろうか?
日本は世界でも最先端の科学立国だ。特に化学(ケミカル)分野は世界トップクラスの実績を上げている。
今回の有効成分は ” アミノ酸 ” である。アミノ酸というと、私たちの身体を構成している成分だ。タンパク質を分解するとアミノ酸になる。そのアミノ酸の一部に化学変化を起こさせたものが、このアミノ酸除菌スプレー『お前のその靴、大丈夫か!?』なのだ。

※映像はわかりやすいように何度も噴射していますが、ワンプッシュでOK!
このアミノ酸除菌は、一般ではまだまだ知られていないが、医療の現場ではよく使われており、医療系の現場でのニーズがあるそうだ。 それだけ安全で完全に除菌が出来る画期的な素材だということだ。

【有効な細菌・カビ】
50万個の菌Aが、全て10以下という検査結果


一般的にカビや細菌が属する菌類は〝 菌糸 ”という配列上構造を取っているが、一つ一つの細胞は酵母のような単細胞生物と同じ構造だ。
このアミノ酸除菌剤は、単細胞生物の細胞壁を破壊する働きがあり、我々のような多細胞生物には影響を及ぼさないと言われている。
つまり、カビなどの小さな微生物を根源からやっつけてしまう力を持っているのだ。


現在、一般に使用されている除菌剤は、アルコール(エタノール)を使用しているのが主流であり、手荒れ、除菌力の持続性が弱い、臭い、引火の恐れ等の危険の問題を抱えながら使用しているのが実情だ。

『お前のその靴、大丈夫か!?』(アミノ酸除菌剤)は、化粧品洗剤原料メーカーの除菌剤のみで、中和剤等の混合物は一切使用されていないから、手や肌に優しく、環境にも優しいのだ。
他の除菌剤と比べて多くのメリットがあるぞ!

雑菌は、20~30度の気温、湿度65%以上になると増殖が促進される。湿度は高いほど、雑菌の繁殖に適している。靴の内部は、密室状態で、足の体温で常に温度・湿度が高い環境だ。雑菌が暴れまくるには絶好の場所といえる!
靴の内部は念入りにクリーニングしない限り、汚れが蓄積しやすい場所になってしまう。カビは汚れを栄養分とするため、汚れもカビの繁殖に関係している。靴の内部の湿気を取り除くことや、汚れを溜めないことが雑菌やカビを繁殖させない方法だといえるのだ。

① 対象物(靴の内部)に向けて、まんべんなくスプレーだ!
② 乾くのを待つ!揮発性の高いアルコールを含んでいないので、2~3分は我慢。
以上。
” 俺はめんどくさいことが嫌いだ!一工程で済ませるのが俺流!!"


〔商品名〕″お前のその靴、大丈夫か!?”
〔主な成分〕水、アミノ酸系活性剤
〔用途〕靴の除菌・消臭
〔使用方法〕対象物に向けて約20㎝ほど離した位置から適量をスプレーする。
〔使用上の注意〕
●乳幼児の手の届くところには置かない。
●ミストを直接吸引しない。
●使用環境によっては効果が感じられない場合がある。
●高温の場所、直射日光の当たる場所には置かない。
●用途外に使用しない。
●荒れ性の方や長時間使用する場合は手袋を使用する。
●気分が悪くなった時は使用を中止する。
●目に入った時は、こすらずに流水で洗い流す。
●誤って飲み込んだ際は、無理に吐かずに口をゆすぎ、水を飲む等の処置をし、医師に相談する。
〔容量〕100ml(本体スプレー)、詰め替えパック(300ml)
〔原産国〕日本

新しいアイテムを日々探求している俺たち!!毎日毎日、足を使って動いていると、一番の悩みは帰ってきた後の靴の臭いだった!! 部屋に戻り、靴を脱いだ後の爽快感!!
しかし、その0.5秒後に襲ってくる激臭の悪夢。

「その悩みを解決したい!」というのが一つの出発点だった。
俺は、普段雪駄しか履いていないのだが、展示会、たまにパーティーや講演会などに呼ばれたときには革靴を履いている。 その後の懇親会で居酒屋などへ行った際に靴を脱ぐ機会も多い。
そんな時、どうしても気になってしまうのが、「俺のこの靴、大丈夫か?」ということ。
特に、女性陣がいるともう気になって仕方がない。 俺たちは日本男児である!!
日本男児は” ジェントルマン ”でなければいかん!
”ジェントルマン ”とは、配慮が出来る男のことをいう。「配慮」とは、人の気持ちを理解して人に相手に気を配り、気持ちの良い時間や場所を提供することである。
俺たち日本男児は、足の臭いに敏感にならねばならん!!
常にカバンの中に忍ばせておけ!


このアイテムは、高機能性の水を開発している「株式会社ダントッツ」との共同開発から生まれた。 ダントッツは、水を科学する会社で、様々な新アイテムを開発してる。 今回、「日本男子の足の臭いをどうにかしたい!!」と企画を持ち込んだところ、快く開発に協力をしてくれた。

株式会社ダントッツ 代表取締役社長 豊田社長
ダントッツの企業スローガンは、「これは使える!ダントッツ」です。 ダントッツでは普段から家庭内での悩みを解決するクリーナーアイテムを製造開発し、主に東急ハンズを中心に販売しています。
今回、雪駄のおっちゃんから「俺の足の臭いが気になって仕方がない。何とか解決するアイテムはないのか?」という無謀な申し入れがあり、それは無理じゃないか?と思ったのですが、開発に協力することになりました。たまたま、弊社が開発中のエアコン除菌クリーナーの成分である、アミノ酸系除菌剤が有効ではないか?という事で、それを元にした特別なレシピを開発しました。皆様の悩みを解決し、「これは使えるねダントッツさん!!」と言ってもらえるような高品質なアイテムを開発します。是非この「おまえのその靴、大丈夫か?」を使って皆様の生活に少しでもお役に立てれば幸いです。

俺は雪駄のおっちゃん。
日本のみならず、世界中を股にかけるプロフェッショナルバイヤー。今回は、日本の最先端科学を駆使したアイテムの開発をみなさん紹介させてもらった。
日本の技術力は本当にすごい!まだまだ可能性を秘めている。俺は、そんなたくさん可能性を一つ一つ紡ぎ合わせて、これまでになり商品開発をしている。
俺はこれからも日本中、世界中を歩き回り、日本の仲間たちに喜んでもらえる最新アイテムやインテリジェンス(情報)を提案したいと思う。 厄年を過ぎた44歳!! 巷では完全におっさんだが、俺はまだまだ俺の夢と日本の仲間たちの為に雪駄で歩き回るぜ!!


一般販売に向け、本格生産を始めるための準備費用に充てさせていただきます。製作費の内訳としては、容器制作代、液体代金、シール・包装代金、加工賃、広告費などになります。また、多くの方にご支援いただいた場合は、次の製品開発の開発費用として充てさせていただきます。
2019年7月末 プロジェクト期間終了
2019年8月末 リターン発送開始
2019年8月 量産開始予定
2019年9月 一般販売予定

Q:においが有るのはいやです。においはどうですか?
A:においは無香料で、無臭に近いです。現在、爽快感を出すためにハッカ油のブレンドも検討しております。ハッカ油が入る場合、スーッとしたさわやかなミントの香りがあります。
Q:手荒れしませんか?
A:化粧品、シャンプー、リンスに使われる殺菌剤を除菌剤に改良した製品で、中和剤等の混合は一切何もしていません。
手に噴霧すると手がすべすべします。
Q:玄関や下駄箱など空間噴霧は出来ますか?
A:玄関、下駄箱など空間にも噴霧可能です。下駄箱の嫌な臭いにも効果を認めます。
Q:消臭もできるのですか?
A:除菌剤(グリシン)の機能により、臭いのもとである菌の基を分解・破壊するため、臭いが無くなります。菌が完全に分解されるまでに時間を要します。
【リスクとチャレンジ】
※量産が進むにつれ、価格の見直しなど変更が出ることがございます。
※細かい仕様・デザインについては予告なく変更になる場合がございます。予めご了承ください。
※ご注文状況や製造工程の都合等により出荷時期が遅れる場合があります。
※消臭については靴等対象物の個体差や消臭の感じ方に個人差が予想される製品でございます。そのため、使用感等に関する返品・返金はお受けいたしかねます。
クラウドファンディングの性質上、以上の注意点につきましてあらかじめご理解とご了承いただいた上でご支援くださいますよう、よろしくお願い申し上げます。
サポーターからの応援コメント
文章のトップに戻る
応援購入する
このプロジェクトはAll or Nothing型です。プロジェクト成立のためにはプロジェクト終了日の2019年07月27日までに目標金額が達成となる必要があります。
【20%OFF】300名様限定割『お前のその靴、大丈夫か!?』1本
1,512円(税込)
Makuake支援者様限定価格!
送付物
『お前のその靴、大丈夫か!?』1本(100ml)
販売予定価格:1,080円(税込)20%OFF+送料
※パッケージデザイン、仕様は変更になる可能性もございます。ご了承ください。
※ご注文状況、使用部材の供給状況、製造工程上の都合等により出荷時期が遅れる場合があります。
【30%OFF】200名様限定『お前のその靴、大丈夫か!?』1本+詰替え1パック
3,218円(税込)
Makuake支援者様限定価格!
送付物
『お前のその靴、大丈夫か!?』1本(100ml)
販売予定価格:1,080円(税込)×30%OFF
詰め替えパック1個(400ml)販売予定価格2,592円(税込)1パック×30%OFF+送料
※パッケージデザイン、仕様は変更になる可能性もございます。ご了承ください。
※ご注文状況、使用部材の供給状況、製造工程上の都合等により出荷時期が遅れる場合があります。
【20%OFF】特別価格『お前のその靴、大丈夫か!?』1本+詰替え1パック
3,585円(税込)
Makuake支援者様限定価格!
送付物
『お前のその靴、大丈夫か!?』1本(100ml)
販売予定価格:1,080円(税込)×20%OFF
詰め替えパック1個(400ml)販売予定価格2,592円(税込)1パック×20%OFF+送料
※パッケージデザイン、仕様は変更になる可能性もございます。ご了承ください。
※ご注文状況、使用部材の供給状況、製造工程上の都合等により出荷時期が遅れる場合があります。
【20%OFF】特別価格『お前のその靴、大丈夫か!?』1本++詰替え2パック
5,660円(税込)
Makuake支援者様限定価格!
送付物
『お前のその靴、大丈夫か!?』1本(100ml)
販売予定価格:1,080円(税込)×20%OFF
詰め替えパック1個(400ml)販売予定価格2,592円(税込)2パック×20%OFF+送料
※パッケージデザイン、仕様は変更になる可能性もございます。ご了承ください。
※ご注文状況、使用部材の供給状況、製造工程上の都合等により出荷時期が遅れる場合があります。
【20%OFF】特別価格『お前のその靴、大丈夫か!?』1本++詰替え3パック
7,736円(税込)
Makuake支援者様限定価格!
送付物
『お前のその靴、大丈夫か!?』1本(100ml)
販売予定価格:1,080円(税込)×20%OFF
詰め替えパック1個(400ml)販売予定価格2,592円(税込)3パック×20%OFF+送料
※パッケージデザイン、仕様は変更になる可能性もございます。ご了承ください。
※ご注文状況、使用部材の供給状況、製造工程上の都合等により出荷時期が遅れる場合があります。
【20%OFF】特別価格『お前のその靴、大丈夫か!?』1本++詰替え5パック
11,880円(税込)
Makuake支援者様限定価格!
送付物
『お前のその靴、大丈夫か!?』1本(100ml)
販売予定価格:1,080円(税込)×20%OFF
詰め替えパック1個(400ml)販売予定価格2,592円(税込)5パック×20%OFF+送料
※パッケージデザイン、仕様は変更になる可能性もございます。ご了承ください。
※ご注文状況、使用部材の供給状況、製造工程上の都合等により出荷時期が遅れる場合があります。
【20%OFF】『お前のその靴、大丈夫か!?』2本+詰替え10パック
22,250円(税込)
Makuake支援者様限定価格!
送付物
『お前のその靴、大丈夫か!?』(100ml)×2本
販売予定価格:1,080円(税込)×20%OFF
詰め替えパック1個(400ml)販売予定価格2,592円(税込)10パック×20%OFF+送料
※パッケージデザイン、仕様は変更になる可能性もございます。ご了承ください。
※ご注文状況、使用部材の供給状況、製造工程上の都合等により出荷時期が遅れる場合があります。
【20%OFF】『お前のその靴、大丈夫か!?』5本+詰替え50パック
105,190円(税込)
Makuake支援者様限定価格!
送付物
『お前のその靴、大丈夫か!?』1本(100ml)
販売予定価格:1,080円(税込)×20%OFF
詰め替えパック1個(400ml)販売予定価格2,592円(税込)50パック×20%OFF+送料
※パッケージデザイン、仕様は変更になる可能性もございます。ご了承ください。
※ご注文状況、使用部材の供給状況、製造工程上の都合等により出荷時期が遅れる場合があります。
「Makuake(マクアケ)」は、実行者の想いを応援購入によって実現するアタラシイものやサービスのプラットフォームです。このページは、 テクノロジーカテゴリの 「【 お前のその靴、大丈夫か!?】男靴の激臭を簡単に撃退するアミノ酸除菌スプレー」プロジェクト詳細ページです。